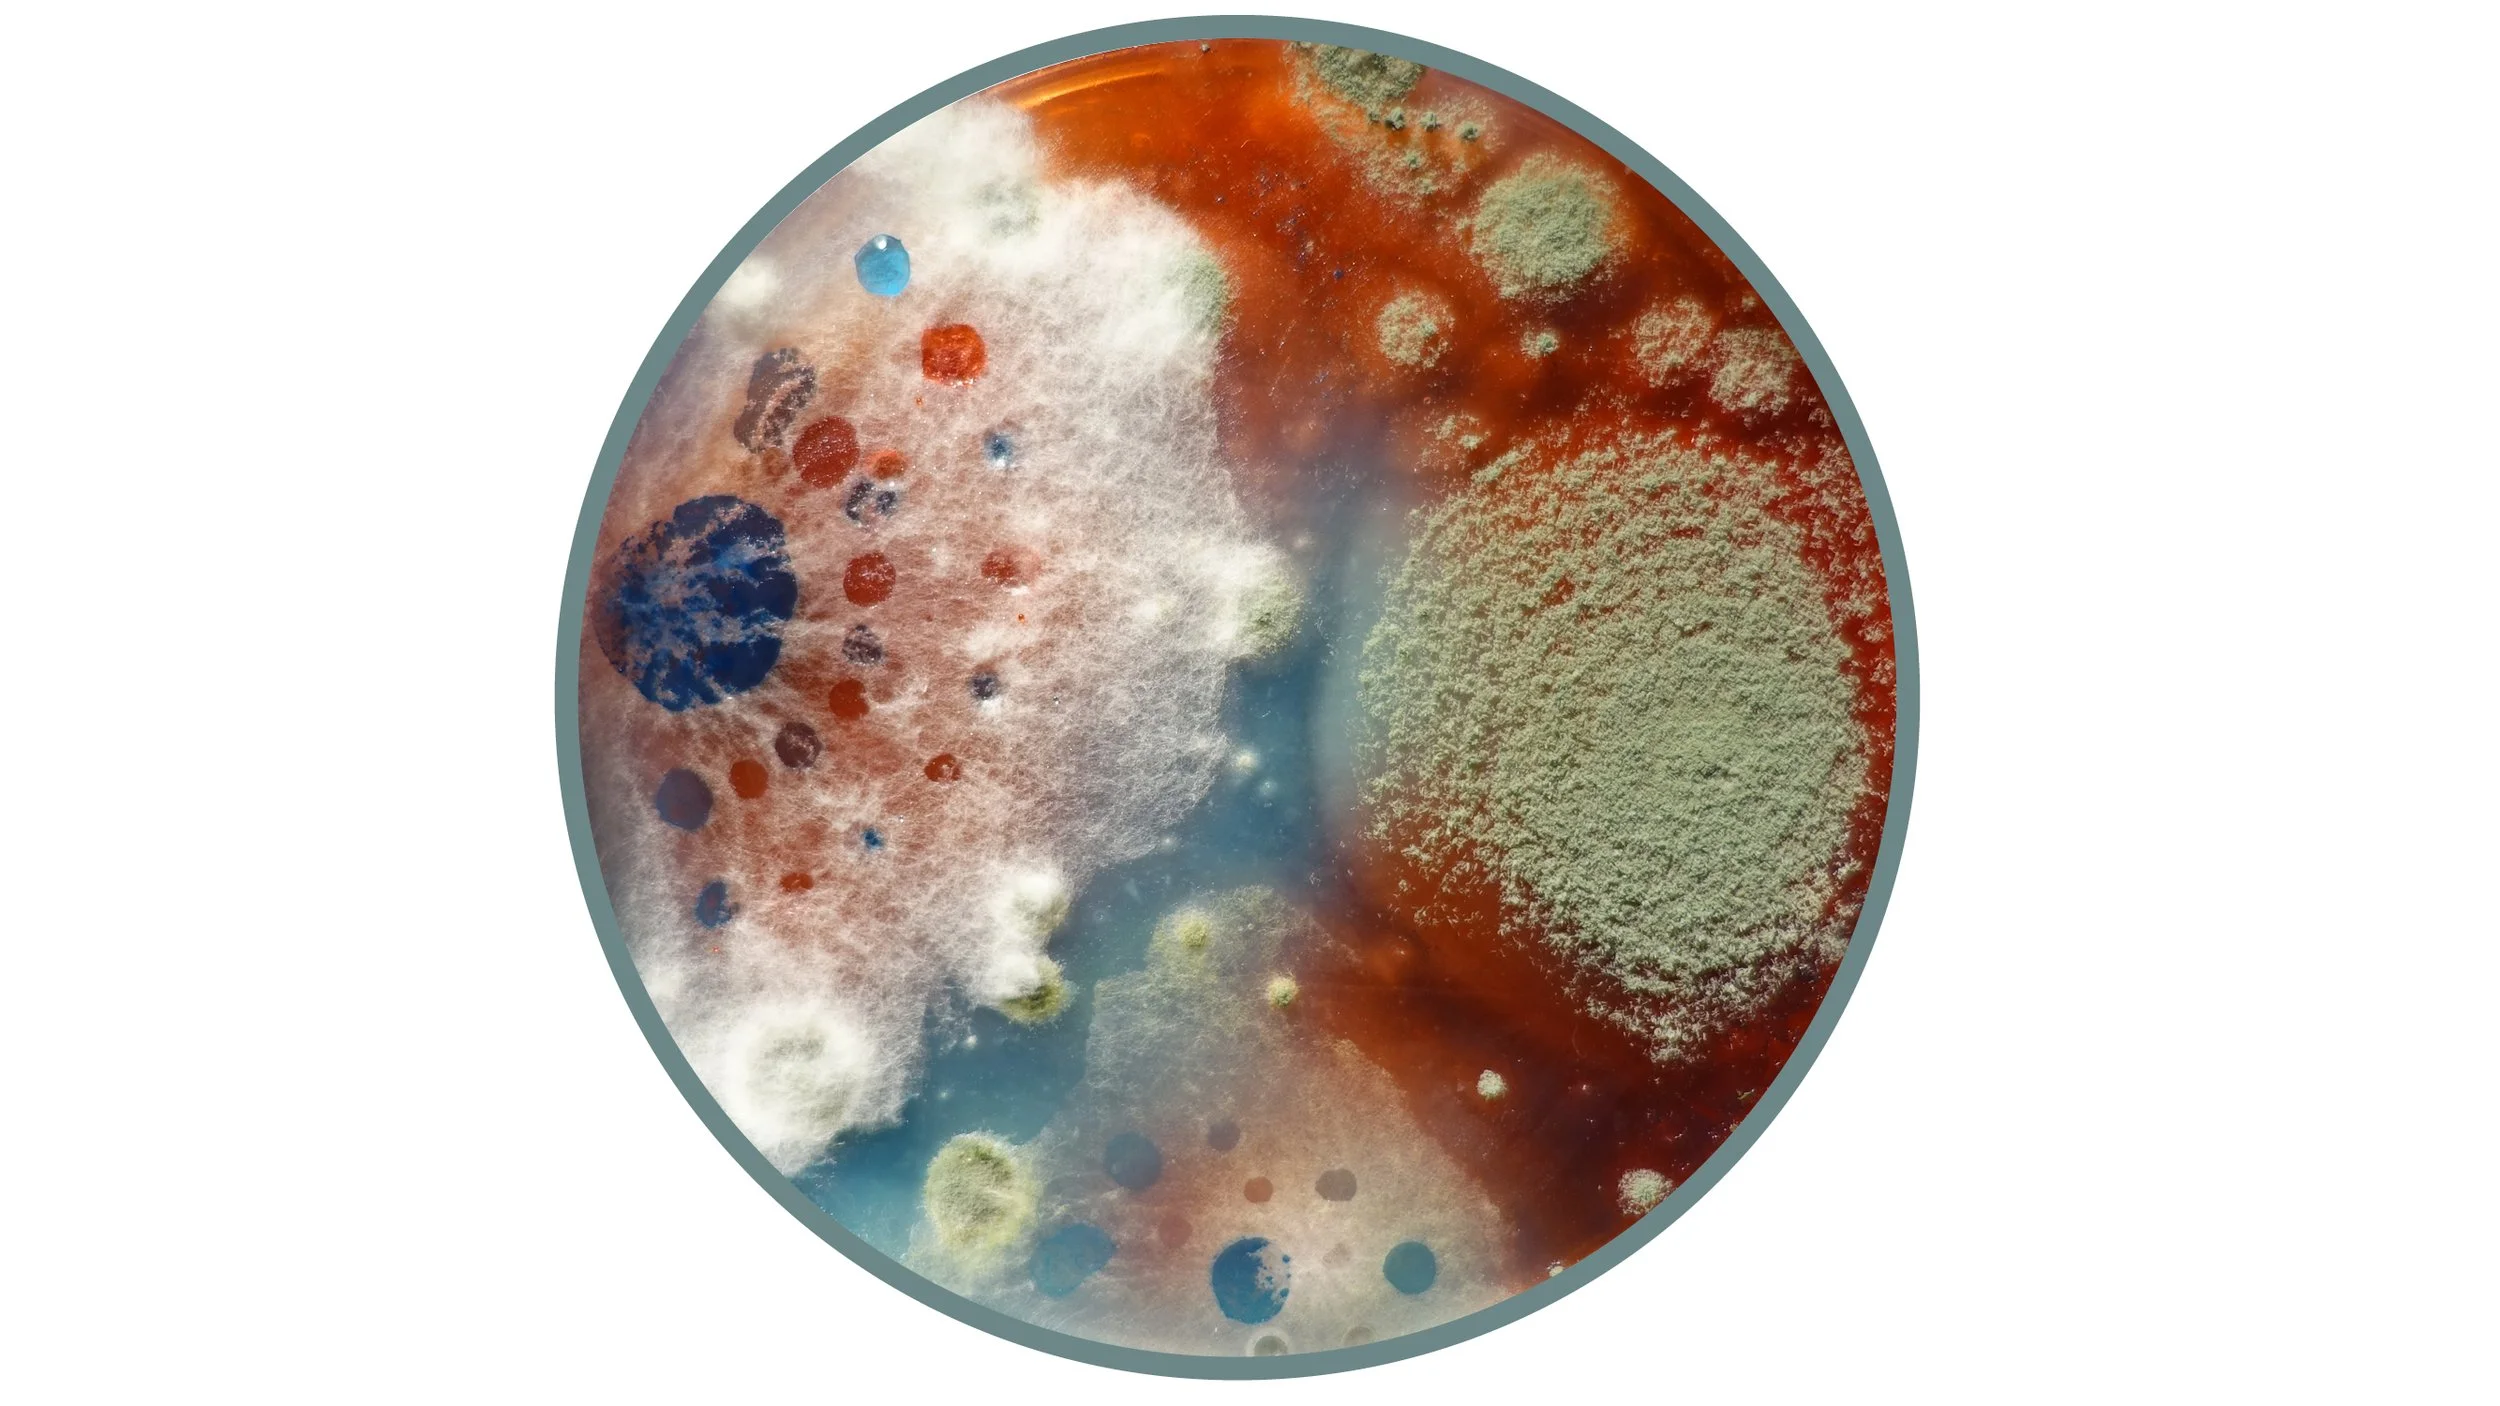

BDC Archive
Since its founding in 2015, BDC has worked with over 100 high schools and colleges in 29 countries. Each June, finalist teams gather at the Museum of Modern Art (MoMA) and Parsons School of Design in New York City to present their projects to the judging panel and a public audience.